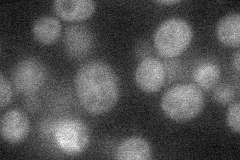
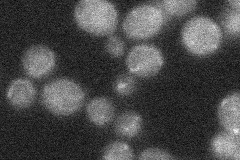
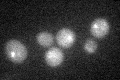

View description
Putative cystathionine beta-lyase; involved in copper ion homeostasis and sulfur metabolism; null mutant displays increased levels of spontaneous Rad52p foci; expression induced by nitrogen limitation in a GLN3, GAT1-dependent manner
Localization:
Intensity:
Fold change:
Significance:
-
C’ GFP library in SD

below threshold17.04 -
N' NOP1pr-GFP in SD
ambiguous20.2817 -
N' TEF2pr-mCherry in SD

below threshold4.64685 -
N' NATIVEpr-GFP in SD
below threshold20.6028 -
N' TEF2pr-VC and Cyto-VN in SD

#N/A0 -
C’ GFP library in SD+DTT
cytosol17.11No -
C’ GFP library in SD+H2O2

cytosol16.940.99No -
C’ GFP library in Starvation Media

cytosol16.080.94No -
C’ GFP library on the background of Pup2-DaMP

below threshold -
C’ GFP library on the background of CCT mutant

below threshold17.03650.999588No
